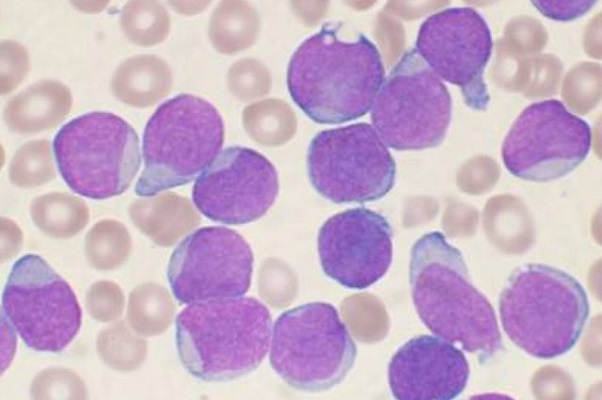
Leucemia infantile cause: troppa igiene favorisce la malattia

Leucemia infantile cause: troppa igiene favorisce la malattia
di Redazione
23/05/2018

Un ricercatore del The Institute of Cancer Research di Londra ha analizzato trenta anni di studi sulla leucemia linfoblastica acuta che colpisce soprattutto i bambini e ha scoperto che troppa igiene ha un impatto significativo sullo sviluppo della malattia.
Leucemia linfoblastica acuta (LLA)
Solo il nome mette i brividi perché questa malattia colpisce i bambini, anche molto piccoli. Questa forma di cancro, molto aggressiva, può essere causata dall'eccessiva igiene. Il primo anno di vita è quello più importante per i bambini e il mancato contatto con alcuni microbi li renderebbe vulnerabili. Mel Greaves, scienziato del Centre for Evolution and Cancer presso The Institute of Cancer Research di Londra, è giunto a questa conclusione dopo aver analizzato gli studi svolti in 30 anni.
Eccessiva igiene causa la leucemia infantile
L'igiene eccessiva, secondo il ricercatore, è solo uno dei tre fattori che causa la leucemia linfoblastica acuta. Il primo riguarda una malformazione genetica che si verifica quando il feto è nell'utero, il secondo è un'infezione che colpisce il bambino che ha trascorso il primo anno di vita in un ambiente sterile. Il sistema immunitario non si sviluppa come dovrebbe esponendo al rischio di leucemia infantile.
Per arrivare a questa conclusione il professor Greaves ha revisionato gli studi sulla malattia e ha dichiarato che ha trascorso più di 40 anni a studiarla. In questo lasso di tempo ci sono stati dei progressi nel trattamento e nella comprensione dell'evoluzione della malattia tanto che i bambini nel 90% dei casi guariscono. Però gli studiosi non riuscivano a capire perché bambini sani sviluppavano la leucemia infantile, la ricerca fornisce una spiegazione credibile.
Genitori troppo attenti all'igiene
I bambini dei paesi industrializzati sono più esposti alla leucemia rispetto a quelli delle aree più povere e non c'entrano l'inquinamento e le razioni elettromagnetiche. Il sistema immunitario non è pronto ad affrontare le minacce delle infezioni. Anche il microbiologo Jack Gilbert, direttore del Centro Microbioma dell'Università di Chicago, ha detto che le abitazioni sterilizzate come gli ospedali non tutelano i bambini. I genitori però non devono sentirsi in colpa visto che i fattori che causano la leucemia linfoblastica acuta sono diversi e non devono allarmarsi perché i dati evidenziano che c'è un caso ogni 2mila bambini.
Articolo Precedente
Intestino sano, la salsa di pomodoro aiuta?
Articolo Successivo
Incinta a 70 anni, donna messicana la mamma più anziana del mondo



